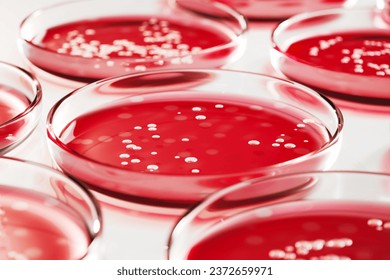
petri dish showing bacterial growth staphylococcus aureus, macro photography, lab setting

Healthcare Infection Risks: Contaminated Lobby Seating
Discover the hidden risks of Gram-positive cocci in facility furniture and why non-porous medical-grade vinyl is essential for pathogen prevention.
BIOLOGICAL THREAT ASSESSMENT: LOBBY SEATING
Evaluation of Pathogen Reservoirs in Current Facility Furniture
BLUF: BOTTOM LINE UP FRONT
Our lobby chairs are currently functioning as biological reservoirs for Gram-positive cocci. Standard cleaning protocols are ineffective on the current porous fabric.
Immediate decommissioning of fabric seating required to prevent potential outbreak vectors.
THE EVIDENCE: LOCAL SAMPLING RESULTS
SAMPLE A: Armrest
SAMPLE B: Seat Cushion
TARGET IDENTIFICATION: GRAM-POSITIVE COCCI
Staphylococcus aureus (MRSA)
Resistant to many antibiotics. Causes severe skin infections, pneumonia, and sepsis.
Enterococcus spp.
Hardy organisms that survive weeks on fabric. Leading cause of surgical site infections.
Streptococcus spp.
Fast-spreading. Causes necrotizing fasciitis and bloodstream infections.
SURVIVAL DURATION ON HOSPITAL MATERIALS
Research indicates Gram-positive cocci can survive for nearly 3 months on our current polyester upholstery.
THE MECHANISM: WHY CLEANING FAILS
Porosity trap: Bacteria penetrate deep into the weave where wipes cannot reach.
Moisture Retention: Cleaning fluids often just create a humid environment that promotes growth.
Re-aerosolization: Sitting on the chair pumps pathogens back into the air and onto clothing.
MEDICAL THREAT 1: SKIN & SOFT TISSUE
Direct contact with contaminated upholstery causes Impetigo and Abscesses.
Surgical wounds are highly vulnerable post-discharge while waiting in the lobby.
MEDICAL THREAT 2: SYSTEMIC INFECTION
SEPSIS & BACTEREMIA
Staphylococcus aureus is a leading cause of community-acquired bloodstream infections with high mortality rates.
IMPACT ON READINESS & FAMILIES
The primary vectors are targeting our most vulnerable populations: dependents (children with developing immune systems) and retirees/veterans (immunocompromised).
THE SOLUTION: NON-POROUS BARRIER
1. Medical-Grade Vinyl (Impermeable) 2. Seamless construction (No hiding spots) 3. Bleach-cleanable surface
RECOMMENDATION: IMMEDIATE REPLACEMENT
Cost of New Seating << Cost of Single Nosocomial Outbreak
REQUEST AUTHORIZATION TO PROCURE VINYL MEDICAL SEATING
- infection-control
- healthcare-safety
- medical-facility-management
- pathogen-prevention
- mrsa
- gram-positive-cocci
- hospital-hygiene